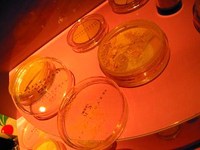

レビュー コスメ
シアー カバー
2011/11/3 (木) 23:40
みこち
評価:★★★★★☆☆
このミネラルファンデは、植物エキスとミネラルのみを配合したふんわりツヤ美肌に仕上げてくれるファンデーションで、特徴は3点あるそうです。
①天然ミネラル「マイカ」の光コントロール効果で、多方向に光を分散しシミや毛穴の凹凸をカバー
②植物性保湿成分「グリーンルイボスティーエキス」がメイクしながら潤いを補給
③無香料・無着色・アレルギーテスト済み・無鉱物油・パラベンフリー・ノンコメドジェニック処方
ふんわりと軽いつけ心地なのに、カバー力は強力!ミネラルパウダーがシミやクマをしっかりとカバーし、植物エキスが潤いをプラス。しっとりうるおうツヤ肌を長時間キープしてくれます。
使い方は簡単3ステップ。
①容器をさかさまにして、ふたの内側に粉を出し、ブラシに少量取ってフタの内側でクルクル~。
②ブラシの柄を下に向け、トントンと打ちつけて粉を毛束全体に含ませる。
③ブラシを顔の中心から外側に向かって円を描くようにふわふわとのせていきます。
ミネラルファンデーションって、肌に厚く塗っている感がなくて、ナチュラルに仕上がる半面カバー力が物足りなかったりするんだけど、これは大丈夫そうでしたよ!
 コメント(0)
コメント(0) パウダーファンデ
パウダーファンデ ガシー・レンカー・ジャパン
ガシー・レンカー・ジャパン ツヤツヤ
ツヤツヤ 戻る
戻る キレイナビ
キレイナビ